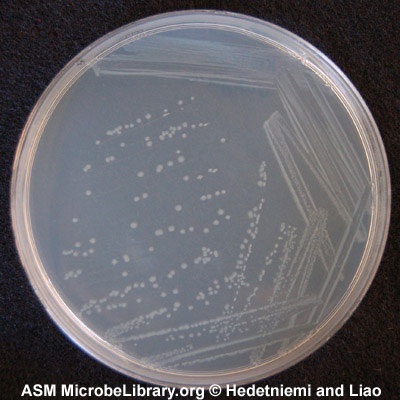

Протей антибиотики
Pentium g620 2.60 ghz
Красноармейская 37 екатеринбург
Векс сайд
Egger st 9
Какие старые игры пройти
Мершед хасан имадович нейрохирург
Слушать музыку для автозвука
Салат с жареной грушей и беконом
1е сентября праздники
Химическая связь углекислого газа
Noir woman
Упражнения планка для похудения как правильно делать
Фамилия лагута
Протей антибиотики 115 фотографий